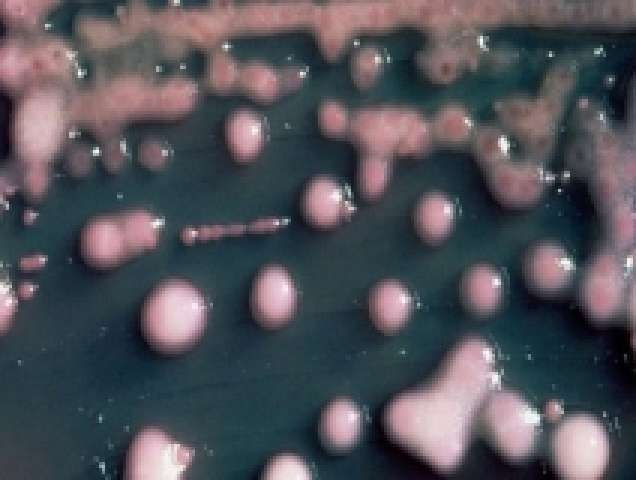

كارثة خطيرة تهدد العالم
حذر تقرير للحكومة البريطانية من انتشار سلالة جديدة من "البكتيريا المقاومة للمضادات الحيوية" تهدد حياة نحو 80 ألف شخص في بريطانيا.
وأشار التقرير -الذي بثته صحيفة "الجارديان" البريطانية على موقعها الإلكتروني- إلى أن نحو 200 ألف شخص من الممكن أن يصابوا بعدوى بكتيرية في الدم في حالة انتشارها على نطاق واسع، إذ أنه لا يمكن للمضادات الحيوية المتاحة حاليا التعامل معها.
وأوضح أنه حتى العمليات الجراحية الروتينية من الممكن أن تصبح امرا عالي الخطورة، نظرا لاحتمال الإصابة بالعدوى، وأن عناصر عديدة من الطب الحديث، مثل عملية زرع الأعضاء، قد تمثل خطورة بالغة.
وأضاف التقرير أنه من المتوقع أن تشهد أعداد البكتيريا، المعقدة بفعل مقاومتها لمضادات الميكروبات، تزايدا ملحوظا خلال الـ 20 عاما القادمة، محذرا من أن مرض الانفلونزا الشائع يمكن أن يصبح "خطيرا" للمصابين به حيث تصبح العقاقير عديمة الفائدة ومن المحتمل تقليص عدد الجراحات الروتينية بسبب خطر الإصابة.
وإلى جانب المخاطر الفورية لهذه السلالة البكتيرية الجديدة، حذر التقرير من احتمال ارتفاع أعداد الوفيات الناجمة عن أشكال أخرى من البكتيريا المقاومة لمضادات الميكروبات.
وأكدت الصحيفة أن هذه التحذيرات وردت في سجل المخاطر الوطني لحالات الطوارئ المدنية، وهي وثيقة أعدها "مكتب رئاسة الوزراء" لتقييم التحديات التي يشكلها الإرهاب والأمراض والكوارث الطبيعية والنزاعات الصناعية.
وللمرة الأولى، يتضمن تقييما للاخطار التي تشكلها مقاومة العقاقير المضادة للميكروبات، والتي يصفها بأنها مسألة "بالغة خطورة" بالنسبة للمملكة المتحدة.
ونوهت التحذيرات أن "هناك مشكلة خطيرة آخذة في التزايد تتمثل في تطور وانتشار بكتيريا مقاومة لمضادات الميكروبات والتي تحدث عندما تفقد العقاقير فعاليتها في علاج العدوى التي تسببها كائنات حية دقيقة".
ويتابع العلماء بقلق متزايد أثر مقاومة مضادات الميكروبات مما يجعل المضادات الحيوية الروتينية أو العقاقير المضادة الفيروسات غير فعالة في علاج الأمراض التي كانت تنجح سابقا في السيطرة عليها.
وسيعني ذلك احتمال ضياع مكاسب ضخمة تحققت منذ اكتشاف البنسلين في السيطرة على الالتهاب الرئوي والسل وتأمين عمليات الجراحة والولادة.
وقد حذر رئيس وزراء بريطانيا ديفيد كاميرون، من أن سيناريو من هذا القبيل يمكن أن يتسبب في انتكاسة العالم وعودته إلى الوراء إلى العصور المظلمة للطب.










.jpg)






